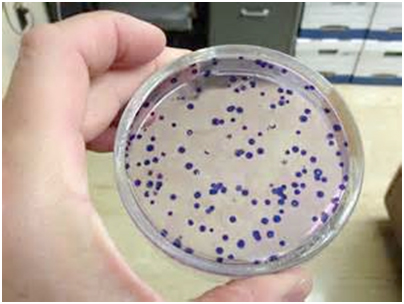

Tags: Scienze
LE CELLULE VIVENTI SONO RESISTENTI O POSSONO RIPARARSI
I Sistemi di Riparazione del Danno da Radiazioni
- di: Francesco Mauro
- Vengono descritti i sistemi di riparazione cellulare del danno indotto da radiazioni ionizzanti che si verifica nelle cellule eucariote e in particolare nelle cellule di mammifero. Una speciale attenzione viene dedicata ai metodi in vitro ed in vivo per riconoscere e misurare in modo quantitativo l’integrità cellulare e molecolare dell’organismo o della popolazione esposta. Questa rivisitazione critica mette in evidenza la presenza di potenti sistemi cellulari naturali di riparazione del danno radioindotto o di parte di esso con conseguenti variazioni della risposta alle radiazioni.
In un precedente articolo pubblicato su l’Astrolabio, il prof. Giovanni Vittorio Pallottino ha preso in considerazione i possibili effetti delle radiazioni ionizzanti a basse dosi, rivisitando in termini aggiornati l’ipotesi dell’ormesi (ossia, che l’esposizione a bassi livelli di dose solleciti l’attivazione delle difese naturali dell’organismo mettendole in grado di proteggerlo più efficacemente in occasione di una successiva esposizione a livelli più elevati) e la questione della presenza o meno di una soglia nella parte iniziale di un curva dose-effetto (assumendo che non si verifichi un danno biologico a dosi più basse di quelle della soglia). Nel presente articolo, viene preso in considerazione un problema in parte collegato, e cioè i fenomeni di riparazione cellulare ed i loro effetti sulla relazione dose-effetto per le radiazioni ionizzanti.
La possibilità di ottenere dati sperimentali che possano chiarire la “forma” della relazione esposizione-effetto a dosi relativamente basse ed indicare l’eventuale presenza di fenomeni quali la radiosensibilità intrinseca, l’ormesi e la riparazione cellulare, dipende dalla disponibilità di “end-point” adatti, ossia di parametri-indice legati a fenomeni biologici chiave che permettano di apprezzare bassi livelli di danno in maniera quantitativa e statisticamente significativa. D’altronde, è tipico della biologia, e in particolare della radiobiologia, che è una disciplina biologica quantitativa nel fondamentale campo della biofisica, di realizzare dei progressi delle conoscenze di valore sia teorico che applicativo grazie alla disponibilità di metodi sperimentali appropriati e sensibili. Spesso non ci si rende conto di quanto la disponibilità ed il meccanismo d’azione collegato ad un determinato end-point possa condizionare la comprensione di un fenomeno.
L’impiego di end-point di questo tipo avvenne, se si vuole, fin dall’inizio delle genetica moderna: i famosi piselli mendeliani (1866) costituivano ceppi di una specie tali da permettere e segnalare la dominanza e la segregazione dei caratteri (i maligni dicono addirittura che i risultati siano stati troppo buoni ancorchè giusti). Anche le colture di batteri in brodo nutriente o su terreno solido con agar (con la crescita osservata a striscio o sulla base della formazione di colonie), metodologie note da tempo e standardizzate da Pasteur e dall’istituto da lui fondato (1887), servirono a sviluppare metodi per studiare popolazioni di cellule singole. La scoperta dei batteriofagi (d’Hèrelle, 1917) estese questo fondamentale approccio ai virus. La disponibilità di questa panoplia di test ed end-point ha permesso lo studio degli effetti delle radiazioni e di altri agenti biologici (compresi farmaci come gli antibiotici) nei vari phyla di esseri viventi dando modo così di apprezzare la fondamentale unitarietà di alcuni meccanismi e, al tempo stesso, la diversità delle risposta fra organismi e fra specie.
Fra il 1911 e il 1933 (anno in cui ricevette il Premio Nobel), Thomas Hunt Morgan e collaboratori dimostrarono il ruolo fondamentale dei cromosomi nell’ereditarietà – anche se il DNA era ancora lontano nel futuro – e quindi della meiosi e della mitosi nella divisione cellulare. Morgan [1] era riuscito nell’impresa anche grazie all’impiego di un nuovo metodo sperimentale: l’uso del moscerino dell’aceto, Drosophila melanogaster, facilmente allevabile, con riproduzione veloce ed ampia progenie, mutazioni facilmente riconoscibili, cromosomi “giganti” politenici(1) molto ben visibili. Non a caso, uno dei suoi collaboratori, Hermann Joseph Muller (anche lui Premio Nobel), nel 1926, dimostrò proprio su questo organismo per la prima volta la mutagenesi indotta da raggi X [2]. Gli inizi della radiobiologia furono quindi caratterizzati dagli studi sulla mutagenesi e sul danno cromosomico (Figura 1); peraltro, erano già noti a dosi più alte fenomeni quali l’induzione di tumori e gravi danni ai tessuti, come indicato dalle patologie che affliggevano spesso gli stessi ricercatori dei primi tempi.
E’ su questi tipi di danno, e sugli agenti alchilanti “radiomimetici” (con effetti simili a quelli delle radiazioni), che si accentrarono le ricerche segrete, condotte soprattutto per impulso britannico, nel corso della Seconda guerra mondiale. Non si sa molto sugli sviluppi della ricerca per applicazioni belliche da parte degli Alleati, e ancor meno per quel che riguarda l’Asse. Per accordo tacito tra le parti, tra gli eserciti in guerra non furono scambiati colpi con armi chimiche, biologiche o radiologiche (come distinte dalle armi nucleari). Il problema degli effetti delle radiazioni ionizzanti emerse in tutta la sua gravità con il bombardamento atomico di Hiroshima e Nagasaki nel 1945. Nonostante la guerra fredda, in Occidente ci fu una spinta verso la “declassificazione” degli studi sulle radiazioni [3]. Negli Stati Uniti, il gruppo più attivo era stato quello di Alexander Hollaender [4], che fin dal 1938 aveva osservato il danno da radiazioni sugli acidi nucleici, mentre altri ricercatori [5] stavano studiando e classificando i diversi tipi di danno sui cromosomi, consistenti in rotture e lesioni cromosomiche e cromatidiche(2). Questi end-point permettevano comunque la definizione di relazioni quantitative dose-effetto in cellule di vari organismi, soprattutto vegetali (Vicia faba e Tradescantia virginiana e, tavolta, persino Nicotiana tabacum) e sul topo, oltre che su Drosophila e sul calabrone Habrobracon, e infine su linfociti umani in sospensione. Hollaender concentrò le ricerche biologiche nei laboratori nazionali di Oak Ridge (1947), che furono il modello per molti centri di ricerca nucleare nel mondo, compreso l’ENEA Casaccia di Roma.

Figura 1 - Aberrazioni cromosomiche indotte dalle radiazioni ionizzanti
Mentre iniziava il lavoro, che sarebbe andato avanti per decenni, di monitoraggio dei sopravvissuti di Hiroshima e Nagasaki, diventavano disponibili le prime curve dose-effetto sperimentali che mostravano in certi casi una “spalla” (in inglese: shoulder) iniziale nella curva. In altre parole, la curva esprime fin dall’inizio una pendenza che gradualmente l’allontana dal livello corrispondente a zero effetti. In questo, la curva con spalla si distingue dalla curva con “soglia” iniziale (in inglese: threshold) dove si osserva una vera regione senza effetti.
D.E. Lea, in una famosa monografia del 1947 [6], aveva cercato di interpretare la forma di queste curve in termini di meccanismi d’azione (“urti” da parte delle radiazioni ionizzanti che colpiscono stocasticamente “bersagli” all’interno della cellula): nonostante la scoperta della struttura e del ruolo del DNA (1953) sembrasse favorire questa interpretazione, la “teoria del bersaglio” si dimostrò non del tutto applicabile; era riuscita però a consolidare il concetto che il problema andava affrontato in termini di biofisica cellulare. Il momento era comunque maturo per la messa a punto di diverse innovazioni metodologiche.
Sul finire del secolo precedente, Walther Flemming aveva messo in luce, mediante nuovi sistemi di colorazione citologica, il ruolo insostituibile della mitosi nella riproduzione cellulare nell’ambito di tessuti o comunque di popolazioni di cellule. Più o meno nello stesso periodo (1873-1884), Giulio Bizzozero - un grande italiano, medico, biologo, istologo, igienista, senatore - aveva riconosciuto la peculiarità di alcuni tessuti proliferanti dei mammiferi adulti in grado di rigenerarsi e ricostituirsi (tipicamente l’epidermide e la mucosa intestinale ed in certi casi le ossa). Nel 1951, Howard e Pelc su Vicia faba, utilizzando una sostanza radioattiva con cui marcare un precursore degli acidi nucleici necessari alla riproduzione cellulare (la timidina marcata con il tritio, isotopo radioattivo dell’idrogeno), furono in grado di distinguere un ciclo cellulare (Figura 2) che si articola in diverse regioni/periodi morfologico-funzionali [7]; nel ciclo cellulare si riconoscono quindi:
- una fase S in cui viene sintetizzato il nuovo materiale ereditario necessario alla riproduzione,
- un intervallo di preparazione alla mitosi (G2 = gap 2),
- una fase di mitosi (M) vera e propria in cui avviene la divisione cromosomica e cellulare, seguita da
- una fase G1 (gap 1) in cui le due cellule-figlie svolgono altre funzioni: è in quest’ultima fase che le cellule possono arrestarsi per diventare dormienti (G0) o anche per morire.
L’esistenza di queste fasi del ciclo cellulare si è dimostrata generale per tutte le cellule e gli organismi eucarioti.
 Figura 2 - Schema del ciclo cellulare (con il “binario lento” delle cellule dormienti).
Figura 2 - Schema del ciclo cellulare (con il “binario lento” delle cellule dormienti).
Un altro metodo, forse ancor più importante dal punto di vista biodosimetrico, venne messo a punto da Puck con i suoi collaboratori Marcus e Ceciura (1956): è il metodo di coltura in vitro di cellule di mammifero (spesso di origine tumorale o embrionale), capaci di proliferare “indefinitamente” e formare colonie (Figura 3) su una superficie plastificata in un terreno di coltura liquido appropriato (in genere addizionato con siero), che permette una titolazione esatta del numero di cellule vitali prima (controllo) e dopo il trattamento [8]: il metodo rende quindi possibile, seminando nelle piastre cellule trattate (irradiate) la determinazione quantitativa di curve dose-effetto riguardanti la morte cellulare, dette appunto curve di sopravvivenza.
Figura 3 - Colonie su piastra di cellule tumorali umane HeLa secondo il metodo di Puck & Marcus (1956): la stragrande maggioranza delle colonie ha origine da singole cellule.
Figura 3 - Colonie su piastra di cellule tumorali umane HeLa secondo il metodo di Puck & Marcus (1956): la stragrande maggioranza delle colonie ha origine da singole cellule.
 Figura 4 - La curva B è la curva di sopravvivenza con “spalla” ottenuta da Puck & Marcus nek 1956 [9]. La curva A è senza “spalla” (vedi testo).
Figura 4 - La curva B è la curva di sopravvivenza con “spalla” ottenuta da Puck & Marcus nek 1956 [9]. La curva A è senza “spalla” (vedi testo).
I sistemi di riparazione in radiobiologia
Determinando in questo sistema sperimentale l’andamento di queste curve, Puck e Marcus pubblicarono [9] quella che sarebbe diventata la curva di sopravvivenza ai raggi X di “forma” standard per i mammiferi (e poi anche per altri organismi). Questa curva di sopravvivenza cellulare ai raggi X appare essenzialmente esponenziale tranne la parte iniziale su grafico semilogaritmico (sigmoide su grafico lineare), definita da una pendenza Do sul tratto lineare, un numero di estrapolazione n a D=0 oppure una dose-quasi-soglia Dq a S=1 (dove S è la frazione di cellule sopravviventi). In altre parole, si ha una curva con una “spalla” – si noti bene, non una “soglia” - che precede un tratto esponenziale.
Inizialmente n venne creduto correlato agli “urti” della teoria del “bersaglio”. Comunque, la pendenza del tratto lineare e l’entità della “spalla” dipendono dalla specificità della specie, del tessuto e dalla condizione metabolica. Per quel che si può vedere, la “spalla” non è una “soglia”, ossia una qualche “pendenza si ha non appena D si allontana da 0”. Curve di sopravvivenza cellulare senza “spalla” si hanno per i neutroni [10] oppure talvolta se si irradiano batteri [11]; l’entità della “spalla” può dipendere dalle condizioni di ossigenazione e nutritive.
Le potenzialità del metodo di Puck vennero sfruttate in modo ottimale da quello che è stato forse il più importante radiobiologo di sempre: Mortimer M. Elkind, a quei tempi al National Cancer Institute degli NIH. Nel suo fondamentale lavoro [12] del 1959, la popolazione cellulare veniva irradiata fino ad una dose all’incirca corrispondente all’inizio del tratto rettilineo della curva di sopravvivenza su grafico semilogaritmico; si attendeva quindi un breve intervallo di alcune ore prima di irradiare nuovamente con dosi graduali: si poteva così osservare la ricomparsa della “spalla” nella curva (Figura 5). In altre parole, le cellule sopravviventi la prima frazione di dose, dato il tempo necessario, risultavano aver riparato il danno subito e potevano ripresentarsi ad una seconda frazione di dose come se non fossero mai state irradiate. Interpretazione: un potente sistema di riparazione cellulare agiva alle basse dosi, iniziando la propria azione riparatrice immediatamente dopo l’irradiazione.
Il fatto che il fenomeno avvenisse alle basse dosi veniva interpretato come un’indicazione che il meccanismo di riparazione era inattivato dalle radiazioni stesse a dosi più alte. Elkind studiò anche la cinetica temporale della riparazione che però esibiva un andamento complesso che sarebbe stato chiarito in seguito. Il fenomeno venne definito come riparazione del danno subletale da radiazioni.
Esso è stato osservato su molti sistemi cellulari eucarioti da Vicia a Saccharomyces [13], in praticamente tutti i sistemi in vitro e i sistemi tumorali in vivo e in vitro; ed è stata anche osservata (Figura 6) la riparazione sequenziale multipla [14].
 Figura 5 - Il classico esperimento di Elkind (1959) con la riparazione del danno subletale (la dose è indicata in R, ossia in Roentgen, la vecchia unità di misura per la dose di esposizione, non più usata dal 1985, data in cui si smise il usare anche il rad, che era una misura di dose assorbita; in maniera assai approssimata, per il caso in figura, si può dire che 1 R = 1 rad = 0.01 Gy) .
Figura 5 - Il classico esperimento di Elkind (1959) con la riparazione del danno subletale (la dose è indicata in R, ossia in Roentgen, la vecchia unità di misura per la dose di esposizione, non più usata dal 1985, data in cui si smise il usare anche il rad, che era una misura di dose assorbita; in maniera assai approssimata, per il caso in figura, si può dire che 1 R = 1 rad = 0.01 Gy) .
 Figura 6 – In questi dati simulati viene indicata la differenza tra la sopravvivenza cellulare ottenuta con una frazione unica di dose di radiazioni e quella ottenuta dopo una dose frazionata: quest’ultima risposta può essere descritta come un cambiamento della pendenza della curva.
Figura 6 – In questi dati simulati viene indicata la differenza tra la sopravvivenza cellulare ottenuta con una frazione unica di dose di radiazioni e quella ottenuta dopo una dose frazionata: quest’ultima risposta può essere descritta come un cambiamento della pendenza della curva.
Si tratta di un dato interessante dal punto di vista della terapia antineoplastica dove la dose del trattamento viene frazionata, soprattutto allo scopo di cercare di diminuire il danno sui tessuti normali. Elkind et al. [15] hanno anche dimostrato che questo tipo di riparazione è difficilmente inibibile. Altri fenomeni appaiono legati al frazionamento della dose:
- la riossigenazione [16],
- la presenza di sottopopolazioni o frazioni resistenti [17],
- la fissazione del danno potenzialmente letale [18],
- il rateo di dose.
La risposta differenziale nel ciclo cellulare
Un ulteriore progresso metodologico permise di descrivere un altro importante fenomeno. L’osservazione di Terasima e Tolmach (1961) [19] che le cellule in fase di mitosi erano meno solidamente adese alla superficie di plastica della piastra rispetto alle cellule in fase G1/S/G2 rese possibile la raccolta di una popolazione cellulare parasincrona (con questo termine si intendono cellule raccolte all’incirca in fase M = mitosi, non esattamente tutte nello stesso momento del ciclo cellulare ma considerabili come quasi sincronizzate) che poteva, una volta riseminata, poi procedere come una coorte per almeno un ciclo cellulare (perdendo gradualmente sincronia per variabilità individuale). Nel riquadro in basso della Figura 7 è indicata, come funzione del tempo dopo la semina delle cellule parasincrone a t = 0 h, l’incorporazione di timidina tritiata (indizio di sintesi del DNA in corso) da cui risulta una fase S approssimativamente tra l’ora 9 e l’ora 18 (della durata quindi di 9 ore); nel riquadro superiore è indicata la frazione di cellule sopravviventi ad un trattamento con 300 rad (circa 3 Gy) per campioni irradiati a diversi tempi della progressione nel ciclo delle cellule parasincrone (i diversi simboli si riferiscono a esperimenti diversi): in tal modo, gli autori hanno potuto dimostrare [19] la grande radiosensibilità delle cellule nella transizione G1/S e nella parte iniziale della fase S, nonchè in M (mitosi), e la relativa radioresistenza delle cellule in fase G1 e G2.
 Figura 7. Risultati ottenuti con una popolazione di cellule HeLa sincronizzate come descritto nel testo. Nello schema a striscia in alto sono indicate in modo approssimato la posizione delle cellule che procedono lungo il ciclo cellulare (la separazione con una linea non verticale delle fasi del ciclo sta indicare la qualità parasincrona della popolazione cellulare). La curva più in basso illustra l’andamento della sintesi del DNA, osservata in tre separati esperimenti (con tre tipi di simboli), mediante la misura delle cellule marcate dalla timidina tritiata come cellule in riproduzione. Nel grafico intermedio è riportata la sopravvivenza cellulare a 300 rad (3 Gy) di raggi X somministrati a diversi tempi nel ciclo cellulare (0 ore corrisponde alla mitosi). Le fluttuazioni della sopravvivenza alla stessa dose di radiazioni si estendono per circa mezza decade del valore della sopravvivenza: la radiosensibilità delle cellule in mitosi o alla transizione G1/S è chiaramente visibile.
Figura 7. Risultati ottenuti con una popolazione di cellule HeLa sincronizzate come descritto nel testo. Nello schema a striscia in alto sono indicate in modo approssimato la posizione delle cellule che procedono lungo il ciclo cellulare (la separazione con una linea non verticale delle fasi del ciclo sta indicare la qualità parasincrona della popolazione cellulare). La curva più in basso illustra l’andamento della sintesi del DNA, osservata in tre separati esperimenti (con tre tipi di simboli), mediante la misura delle cellule marcate dalla timidina tritiata come cellule in riproduzione. Nel grafico intermedio è riportata la sopravvivenza cellulare a 300 rad (3 Gy) di raggi X somministrati a diversi tempi nel ciclo cellulare (0 ore corrisponde alla mitosi). Le fluttuazioni della sopravvivenza alla stessa dose di radiazioni si estendono per circa mezza decade del valore della sopravvivenza: la radiosensibilità delle cellule in mitosi o alla transizione G1/S è chiaramente visibile.
Negli anni successivi, altri sistemi clonogenici (così viene chiamato l’equivalente in vivo della capacità di formare colonia) vennero messi a punto permettendo l’estensione degli studi radiobiologici con particolare riferimento alle differenze di radiosensibilità tra tessuti (misurate sia in termini di radiosensibilità intrinseca, ossia come Do, cioè pendenza del tratto rettilineo della curva di sopravvivenza), che come capacità di riparazione (ossia come forma e entità della parte iniziale della “spalla” della curva):
- cellule di linfoma trapiantate nel topo che formano colonie in alcuni organi [20];
- cellule emopoietiche trapiantate su topi irradiati: formazione di colonie spleniche (Figura 9, [21]);
 Figura 9. Colonie sulla superficie di una milza di topo formate da cellule staminali emopoietiche (equivalenti alle unità che formano colonia in vitro).
Figura 9. Colonie sulla superficie di una milza di topo formate da cellule staminali emopoietiche (equivalenti alle unità che formano colonia in vitro).
- epidermide e cripte intestinali del tenue di topo: ripopolamento cellulare [14];
- epidermide umana irradiata per terapia: ripopolamento cellulare [22].
Questa varietà di sistemi sperimentali è stata essenziale nel chiarire vari aspetti della risposta alle radiazioni:
- la risposta al frazionamento della dose ed eventualmente a ratei di dose molto bassi: appare governata dalle “5R” (o 4 secondo altri):
- riparazione,
- riassortimento (per la risposta differenziale nel ciclo cellulare di una popolazione asincrona),
- riossigenazione,
- reclutamento (di cellule dormienti Q o G0),
- ripopolamento;
- chiaramente, la presenza di tutti questi fenomeni coinvolti nella risposta alle esposizioni frazionate e le differenze intrinseche e proliferative tra le varie popolazioni cellulari indicano quanto sia difficile e approssimativo, specialmente in vivo, valutare gli effetti di dosi cumulative;
- l’efficienza, robustezza e universalità dei sistemi di riparazione ed il loro radicamento nei sistemi molecolari che presiedono alla riparazione dello stesso DNA e degli organelli essenziali alla riproduzione cellulare;
- la presenza di questi meccanismi ciclo-dipendenti (Figura 10) anche nel caso di almeno una frazione dei tanti agenti non-radiologici [23] - come agenti alchilanti, inibitori delle sintesi, antimitotici, inquinanti, agenti antineoplastici, antibiotici, alcuni agenti fisici non-ionizzanti, ecc. – ma, in certi casi, con alcune differenze nella “forma”delle curve (talvolta con curve simili a quelle indotte dai raggi X, talvolta con “spalla negativa”, forma iperbolica, ecc. [24]).

Figura 10 – In uno stesso esperimento come quello sopra descritto con cellule sincronizzate, è illustrata la risposta ciclo-dipendente ad alcuni agenti antineoplastici che sono degli alcaloidi in grado di danneggiare il meccanismo della mitosi e esercitare, come evidente dal grafico, una azione citotossica sulle stesse cellule.
Il modello lineare-quadratico
Tornando alle basse dosi di radiazioni, in tempi più recenti si è tentato di interpretare l’andamento delle curve di sopravvivenza cellulare alle radiazioni mediante il cosiddetto modello lineare-quadratico, basato sull’assunzione che la risposta biologica possa essere descritta da un’equazione con due componenti principali, una che è proporzionale alla dose e l’altra che è proporzionale al quadrato della dose. Il modello si basa su alcune osservazioni della morte mitotica di cellule di mammifero. Questo tipo di danno appare associato ad aberrazioni cromosomiche del tipo dello scambio asimmetrico (ad esempio, cromosomi dicentrici o cromosomi ad anello) che richiedono due rotture cromosomiche per ottenere questo effetto [25]. Secondo questo modello, la curva di sopravvivenza per frazioni singole di dose viene espressa con l’equazione:
S = e-(αD+βD2)
dove S è la frazione sopravivente, D è la dose frazionale, la costante α è l’inattivazione cellulare in loge per Gy della componente lineare, e la costante β è lo stesso parametro per Gy2 della componente quadratica della curva di sopravvivenza. E’ necessario sottolineare che la formula lineare-quadratica non è sempre compatibile con le osservazioni sulle curve di sopravvivenza. Inoltre, la curva di sopravvivenza, quando messa su grafico semilogaritmico secondo il modello lineare-quadratico, continua a piegare con l’aumentare della dose, cosa che è in contrasto con la maggior parte dei dati che descrivono un declino esponenziale della sopravvivenza cellulare alle alte dosi. Molti tentativi sono stati portati avanti per modificare parzialmente il modello ed evitare questo problematico andamento anche a fronte dell’interesse del possibile uso del modello nel programmare trattamenti di tumori con frazionamenti convenzionali e non [26]. Comunque, in genere, i tentativi di introdurre nel modello modificazioni tali da permettere la previsione dell’entità della riparazione in funzione del tempo, non hanno spesso avuto successo [27].
La forma stessa delle due curve, che corrispondono alla risposta delle due componenti, comporta comunque che la componente β – quella con spalla - sia caratterizzata dall’accumulo di danno da radiazioni e sia quindi quella che può riparare il danno. In questo quadro, è il rapporto α/β che governa la risposta alle radiazioni; tale rapporto varia con la progressione nel ciclo cellulare o anche con lo stato di proliferazione o di dormienza delle cellule che sono caratterizzati da diversi valori delle due costanti e quindi dalla variazione del rapporto tra le stesse. Le conseguenze di questo quadro sono bifronti: l’assenza di una qualsiasi “soglia” iniziale ma, al tempo stesso, potenti sistemi di riparazione a disposizione della cellula.

Figura 11. Una curva di sopravvivenza scomposta indicare le componenti α e β secondo il modello lineare-quadratico.
Il quadro complessivo sembra essere quello di molteplici livelli di danno cellulare, sempre più individuati e descritti, ma in ogni caso soggetti a fenomeni di riparazione e modulazione del danno:
• Danno molecolare; effetti sulla permeabilità cellulare (test di esclusione del colorante); danni su lisosomi, mitocondri, cloroplasti;
• Inibizione della sintesi di DNA (proliferazione), RNA, proteine;
• Rotture cromosomiche, cromatidiche e del DNA, ricongiungimento, aberrazioni,
• Mutagenesi, induzione di mutazioni punto; trasformazione neoplastica: carcinogenesi,
• Effetti su centriolo e fuso, mitosi, ciclo, riproduzione cellulare, ritardi di crescita, formazione di cellule giganti;
• Morte cellulare riproduttiva, programmata (apoptosi), acuta (lisi);
• Effetti su tessuti: morte, riassortimento, reclutamento, ripopolamento; disturbi dell’embriogenesi, malformazioni, teratogenesi; malattia da radiazioni (pelle, mucose, sistema germinale, nervoso, ecc.); invecchiamento, accorciamento della vita, morte dell’organismo.
Alcuni autori (L.A. Ilyin & O.P. Pavlosky, comunicazione personale) del post-Chernobil aggiungono a questa lista la cosiddetta “radiofobia”, ossia il rifiuto incontrollabile di trovarsi in zona contaminata anche se l’esposizione non raggiunge limiti di rischio importanti; i suddetti autori valutano che il fenomeno non sia un semplice effetto psicologico dovuto a carenza di informazione o comprensione, ma possa essere un vero e proprio fenomeno dovuto all’esperienza traumatica di trovarsi esposto a radiazioni di origine non naturale o percepita come tale.
Discussione
Come si vede, per molti di questi end-point, il quadro conoscitivo degli effetti delle radiazioni è stato sostanzialmente completato nell’arco di 30 anni, dalla fine della guerra al 1975, grazie ai metodi sperimentali messi a punto. Rimane però spazio per ulteriori ricerche di importanza o comunque necessarie per stabilire l’eventuale contorno di un fenomeno, come quelle sull’ormesi (vedi sopra) e le indagini sulle cellule bystander. Queste ultime sono cellule non irradiate, ma prossime a cellule irradiate, che mostrano un qualche effetto delle radiazioni. L’osservazione [28] che tra questi effetti rientra la cancerogenesi in vivo (nel topo) potrebbe avere implicazioni per la radioprotezione.
Sul piano applicativo, ci sono state ripercussioni degli studi sulla sopravvivenza cellulare in termini sia di radioprotezione che di radioterapia (e chemioterapia) dei tumori. Nei decenni successivi, l’innovazione metodologica ha continuato a rendere possibili ulteriori approcci sperimentali, che però hanno riguardato più che altro aspetti biotecnologici. Per lo studio degli effetti delle radiazioni e degli altri agenti nocivi fisici e chimici, sono stati importanti i metodi basati sulla citologia analitica, utilizzati anche per il monitoraggio del ciclo cellulare e per lo studio di popolazioni tumorali eterogenee e del sistema germinale maschile.
Rimane aperto un problema di fondo, di interesse in termini evolutivi e forse anche, in un futuro più o meno prossimo, per i risvolti pratici. La presenza ubiquitaria nelle cellule delle specie eucariote del pianeta Terra di potenti sistemi di riparazione e di condizioni di radio resistenza, che operano nell’ampio intervallo che va da dosi estremamente basse (dell’ordine di grandezza di quelle caratteristiche della radioattività naturale e di una ipotetica ormesi) fino a dosi considerevolmente alte (diciamo fra la tipica frazione radioterapica, 2 Gy, e la “fine della spalla” della tipica curva di Elkind, 5 Gy), pone il problema del quadro evolutivo in cui questi sistemi, notevolmente sofisticati in termini molecolari, abbiano rappresentato un vantaggio.
In termini ancora più ampi, le cellule terrestri appaiono “resistenti” ad una varietà di insulti e di condizioni estreme: calore, pressione, vibrazioni, aridità, salinità, freddo, congelamento, ipossia, acidità, alcalinità, irraggiamento ultravioletto, luce visibile, assenza di luce, radiazioni ionizzanti, microonde, radiofrequenze, gravità bassa o assente, ecc. Le cellule eucariote sono robuste e capaci di sopportare o recuperare danni ingenti e situazioni estreme. Le origini, evoluzione e rilevanza di questa situazione merita ulteriori indagini in un quadro sia teorico che applicativo.
Ringraziamenti
Chi scrive è estremamente grato ai propri supervisori, colleghi e collaboratori grazie ai quali gli è stato possibile lavorare in un campo così difficile e rilevante. Essendo di fatto pressoché impossibile ricordarli tutti, coglie l’occasione per ricordare la figura del proprio supervisore al National Cancer Institute di Bethesda, il riconosciuto “padre” della Radiobiologia Cellulare, Mortimer M. Elkind. Ringrazia anche il prof. Gian Vittorio Pallottino per lo stimolo critico che ha facilitato la stesura di questo articolo.
Note
(1) Cromosomi che, a seguito di un eccesso di replicazione, hanno formato un alto numero di cromatidi che rimangono uniti, rendendo così visibile la struttura cromosomica a bande; è il caso dei cromosomi delle ghiandole salivari di molti Ditteri tra cui Drosophila.
(2) Ogni cromosoma possiede due copie lineari dette cromatidi che formano il cromosoma stesso.
Riferimenti
[1] T.H. Morgan. The origin of nine wing mutations in Drosophila. Science 33: 496-499, 1911.
[2] H.M. Muller. Artificial transmutation of the gene. Science 66: 84-87, 1927.
[3] L.H. Gray. Comparative studies of the biological effects of x-rays, neutrons, and other ionizing radiations. Br. Med. Bull. 4: 11-18, 1946.
[4] A. Hollaender. Radiation Biology. McGraw-Hill, New York, 1954.
[5] K. Sax. Types and frequencies of chromosomal aberrations induced by x rays. Cold Spring Harbor Symp. Quant. Biol. 9: 93-101, 1941.
[6] D.E. Lea. Actions of Radiations on Living Cells. Cambridge University Press, London and New York, 1947.
[7] A. Howard & S.R. Pelc. Synthesis of deoxyribonucleic acid in normal and irradiated cells and its relation to chromosome breakage. Heredity Suppl. 6: 261-273, 1953.
[8] T.T. Puck, P.I. Marcus & S.J. Cieciura. Clonal growth of mammalian cells in vitro: Growth characteristics of colonies from single HeLa cells with and without a feeder layer. J. Exp. Med. 103: 273-283, 1956.
[9] T.T. Puck & P.I. Marcus. Action of x-rays on mammalian cells. J. Exp. Med. 103:653-666, 1956.
[10] G.W. Barendsen. Dose survival curves of human cells in tissue culture irradiated with alpha-, beta-, 20 kV x-, and 200 kV x-radiation. Nature 193: 1153-1155, 1962.
[11] R.H. Haynes. The interpretation of microbial inactivation and recovery phenomena. Radiat. Res. Suppl. 6: 1-29, 1966.
[12] M.M. Elkind & H. Sutton. X-ray damage and recovery in mammalian cells in culture. Nature 184: 1293-1295, 1959.
[13] S. Bacchetti & F. Mauro. Recovery from sublethal X-ray damage in surviving yeast cells. Radiat. Res. 25: 102-114, 1965.
[14] H.R. Withers & M.M. Elkind. Radiosensitivity and fractionation response of crypt cells of mouse jejunum. Radiat. Res. 38: 593-613, 1969.
[15] M.M. Elkind, H. Sutton-Gilbert, W.M. Moses, T. Alescio, & R.W. Swain. Radiation response of mammalian cells grown in culture. V. Temperature dependence of the repair of X-ray damage in surviving cells (aerobic and hypoxic). Radiat. Res. 25, 359–376, 1965.
[16] L. M. van Putten & R. F. Kallman. Oxygenation status of a transplantable tumor during fractionated radiation therapy. J. Natl. Cancer Inst. 40: 441-451, 1968.
[17] W.E. Powers & L.J. Tolmach. A multicomponent X-ray survival curve for mouse lymphosarcoma cells irradiated in vivo. Nature 197: 710-711, 1963.
[18] J.B. Little. Repair of sub-lethal and potentially lethal radiation damage in plateau phase cultures of human cells. Nature 224: 804-806, 1969.
[19] T. Terasima & L.J. Tolmach. Changes of X-ray sensitivity of HeLa cells during the division cycle. Nature 190: 1210-1211, 1961.
[20] H.B. Hewitt & C.W. Wilson. A survival curve for mammalian cells irradiated in vivo. Nature 183: 1060-1061, 1959.
[21] E.A. McCulloch & J.E. Till. The radiation sensitivity of normal bone marrow cells determined by quantitative marrow transplantation into irradiated mice. Radiat. Res. 13: 115-125, 1960.
[22] G. Arcangeli, F. Mauro, C. Nervi & H.R. Withers. Dose-survival relationship for epithelial cells of human skin after multifraction irradiation: Evaluation by a quantitative method in vivo. Int. J. Radiat. Oncol. Biol. Phys. 6: 841-842, 1980.
[23] F. Mauro & H. Madoc-Jones. Age responses of cultured mammalian cells to cytotoxic drugs. Cancer Res., 30: 1397-1408, 1970.
[24] M.C. Berenbaum. Dose-response curves for agents that impair cell reproductive integrity: A fundamental difference between dose-response curves of antimetabolites and those for radiation and alkylating agents. Br. J. Cancer 23:426–433, 1969.
[25] H. Withers. Biologic basis for altered fractionation schemes. Cancer 55: 2086–2095, 1985.
[26] M Astrahan. Some implications of linear-quadratic-linear radiation dose-response with regard to hypofractionation. Medical Phys. 35: 4161-4172, 2008.
[27] Z. Huang, N.A. Myr, S.S. Lo, J.Z. Wang, G. Jia, W.T.C. Yuh & R. Jonke. A generalized linear-quadratic model incorporating reciprocal time pattern of radiation damage repair. Med. Phys. 39: 224-237, 2012.
[28] M. Mancuso, E. Pasquali, S, Leonardi, M.Tanori, S. Rebessi, V. Di Majo, S. Pazzaglia, M.P.Toni, M. Pinpinella, V. Covelli & A. Saran. Oncogenic bystander radiation effects in Patched heterozygous mouse cerebellum. PNAS 105: 12445-12450, 2008.

